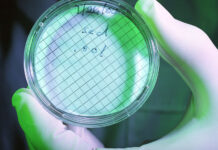
美国得克萨斯州水中现可怕“食脑虫” 丨国际热点速递

美媒称特朗普10年没缴纳所得税丨国际热点速递
美国——特朗普回应漏税当地时间27...
美国得克萨斯州水中现可怕“食脑虫” 丨国际热点速递
美国——自来水遭致命微型变形虫入侵...
刚刚!黄之锋被捕!丨国际热点速递
中国——黄之锋被捕!据香港“星岛网...
特朗普称美国新冠死亡数破20万是耻辱丨国际热点速递
美国——特朗普回应美国死亡病例突破20万...
男子迷上整形,将自己打造成现实版外星人!|趣观世界
今日份的趣观来咯
赶紧跟上大部队
一起看看今天...
传承千年的制盐技术,5道工序就能搞定!|闲话海南
“凿平岩石伴泥田,棋布星罗叠玉盘。
粒粒晶莹犹皓...
96110来电一定要接听丨国际热点速递
中国——全国统一预警劝阻咨询电话96110...
给特朗普寄含蓖麻毒素信的嫌犯被捕丨国际热点速递
美国——涉嫌向特朗普寄毒信女子已被捕...
光荣属于英雄的中国人民丨国际热点速递
中国——勿忘九一八己亥大疫起,庚子...
海南水果怎么吃?统统辣椒盐伺候!|闲话海南
“小妹,要辣椒盐啵?”在海南买水果,总少不了被这样...